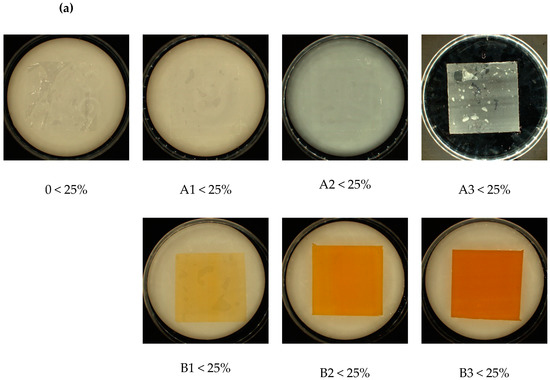

Abstract
With continuous development of biodegradable polymers, new areas of applications are intensively researched. Modifications of these polymers are commonly conducted by an extrusion compounding process. While additives are changing desired properties, biodegradability of such composites can be deteriorated. The aim of the work is to investigate a novel, functional, organic additive, riboflavin (vitamin B-2), in terms of thermal stability, extrusion processability, wettability, surface energy, especially biodegradability, and when compounded with PLA. Additionally, a comparison of unmodified PLA resin, as well as PLA-modified with inorganic talc—which is known for its nucleation promotion in a variety of polymers—to PLA with riboflavin, was presented. Research reveals the outstanding thermal stability of riboflavin and the sufficient extrusion process properties with no significant changes of wettability and, surprisingly, a significant degradation rate as compared to pure PLA or and PLA with talc. The obtained results do not exclude further modifications of PLA depending on the target application, e.g., antimicrobial agents, flame retardants, etc.
1. Introduction
The development of the biodegradable plastics market observed in recent years contributes to the modification of known materials in terms of reducing production costs, improving physical and mechanical properties, or giving them other properties as intended, e.g., ensuring appropriate barrier properties, flame retardancy, etc. Any modification changes the biodegradation potential of the material after its use. Researchers have repeatedly raised the problem of the degradation of bioplastics in the environment, contrary to their original purpose [1,2,3]. It is a pioneering use of a vitamin as an additive to biodegradable plastics with the use of common methods of plastics processing (extrusion). Due to its natural origin, according to the hypothesis, it should not adversely affect the biodegradation processes, but it was necessary to check how the selected riboflavin concentrations affect this process. The most popular polymer of natural origin is polylactide (PLA), which is called “double green” due to its synthesis from ingredients of natural origin, as well as the assumption of biodegradation potential in the natural environment [4].
As it turned out, contrary to expectations, often, biodegradable polymer materials are very difficult to degrade in the natural environment, for example in soil, seas, and oceans [5,6]. In principle, PLA should undergo complete biological degradation within 6 to 24 months [7,8], because aliphatic ester compounds, including PLA, are relatively easy to hydrolyze [9]. However, studies have shown that the decomposition of PLA in an environment other than compost is very slow [10,11]. This polymer is less degraded by microorganisms than other aliphatic polyesters, such as polycaprolactone (PCL) [7,12].
The degree of decomposition of the polymeric material in the environment, among others in soil, to a large extent, depends on the fertility of the soil, which is determined by its physicochemical properties and its biological activity, i.e., the intensity of the processes of transformation of organic and mineral substances catalyzed by microorganisms [13]. While fertility of soil can differ, it can be visible in comparison of the same materials and by finding significant differences in the level of biodegradation and the time of achieving similar results in individual tests. This presents a problem when comparing results between and within tests. For this reason, the following studies include tests of modified PLA both in the presence of soil microorganisms and in the presence of other microorganisms, as indicated by the methodology in the international ISO standard [14].
In recent years, PLA has become a relatively frequent subject of research. On the one hand, chemists and material engineering specialists are working on modifications that improve the biodegradation potential of the material [15,16,17]. On the other hand, biologists in various environments are looking for microorganisms that accelerate its decomposition [18,19,20].
PLA and other biodegradable polymers, due to their properties, are commonly investigated as packaging [21], single-use assortments [22], and medical material applications [23]. With, nowadays, a bigger concern for the environmental impact of material chemistry and engineering, researchers take more and more efforts in transforming biodegradable polymers into highly specialized composites with possibilities of use in the construction of sophisticated devices [24].
Among the many directions of development of polymer compositions, particular attention is paid to the possibility of using them for the production of materials with certain piezoelectric properties. The obtained positive results of both the biodegradation of the entire material and the thermal stability of riboflavin itself allow for taking steps towards the development of a material with piezoelectric properties, although this would not be the only possibility of using the obtained results in practice. Features, such as good mechanical properties; relatively low density compared to the currently used piezoelectric materials, which allows the production of parts with low weight; the possibility of forming any shape with affordable processing methods; resistance to external factors; ease of processing; and modification treatments, are involved to improve the piezoelectric response of conventional polymers [25,26].
Due to the fact that the currently used ceramic piezoelectric materials have a structure that can be described as asymmetric–crystalline with a high level of crystallinity, when designing a polymer composite, one should strive to organize the structure as much as possible. PLA, as a semi-crystalline material capable of forming crystal complexes, seems to be the most appropriate choice among biodegradable polymers.
According to many scientific studies, the level of crystallinity of pure PLA is not high, and the time needed to produce the crystallites is long. One of the methods of improving and accelerating crystallization is modification of the composites by introducing nucleating agents into the polymer matrix. Commonly used nucleants, both for conventional and biodegradable plastics, are fine or talc [27,28].
While talc is a natural, inorganic mineral material, the authors looked for natural organic substances that would cause a similar nucleation effect, and that, at the same time, would be non-toxic for living organisms and would not hinder biodegradation, or even improve it. A substance called riboflavin, more widely known as vitamin B2, aroused interest, and is the subject of this study. Unlike talc, which is known for its high thermal stability, the compounding processability and nucleation activity of vitamin B2 is unknown. There is only one publication known to the authors of the improvement of PLA crystallization by riboflavin [29]. What is more, the detailed article brings composites preparation by the solvent method only, where screw shear forces, as well as high temperature and pressure rise, and characteristics for extrusion processes, do not occur.
Therefore, in this article, a novel application of riboflavin as biodegradation accelerator agents is reported. However, the effects of crystallization on improving mechanical and piezoelectric properties will be the subject of further, separate publications.
2. Materials and Methods
2.1. Materials
Polylactide (PLA) in the form of 150–300 µm approx. sized grains, obtained from Luminy® PLA LX 175 (Total-Corbion, Gorinchem, The Netherlands), with a grade melt flow ratio 3 g/10 min. (2.16 kg, 190 °C) and a density of 1.24 g/cm3, according to ISO 1133A [30]. Additionally, 100% pure food grade riboflavin (Food Colours, Piotrków Trybunalski, Poland) and lamellar talc in form of fine powder—Fintalc M04SLC (Elementis Minerals, Amsterdam, Netherlands)—were used.
2.2. Material Processing
Before composites and films extrusion, initial testing of thermal properties of riboflavin were investigated to prove that this new natural additive can resist the temperature applied in the extrusion processes. Thermal stability was evaluated by the thermogravimetry (TG) method using a Thermogravimeter Q 500 (TA Instruments, New Castle, DE, USA). Composites were heated from up to 900 °C at a rate of 10 °C/min under nitrogen flow, according to the PN-EN ISO 11,358 standard [31].
For composite preparation purposes, a laboratory single-screw extruder manufactured by Research Network Lukasiewicz—Institute for Engineering of Polymer Material and Dyes, Toruń, Poland, with a 14 mm screw diameter and 27 L/D ratio was used. Parameters of composite extrusion are listed in Table 1.
Table 1.
Parameters of composite extrusion.
The films were extruded from the granulate using a laboratory processing line consisting of a Plasti-Corder PLV 151 single-screw extruder (Brabender, Duisburg, Germany) with a 19 mm screw diameter, a 25 L/D ratio, a 3:1 compression ratio, a slot-die head with a working width of 100 mm and a gap height of 0.1 mm, and a water-cooled three-roller system with a roller diameter of 110 mm. Additionally, the extruder was equipped with the apparatus necessary to measure the temperature of the heating zones of the plasticizing system and the extruder head.
For the tests, samples containing raw materials and their concentrations were used, as shown in Table 2.
Table 2.
Samples and raw materials used for the research. Abbreviations: 0—control (PLA without additives); A1–A3—samples with 1%, 5%, and 20% of talc, respectively; B1–B3—samples with 1%, 5%, and 20% riboflavin, respectively.
During the extrusion of the individual polymer films, the temperature of the extruder zones, the temperature of the head, and the rotational speed of the screw were controlled. Moreover, rotational speed of the screw was adjusted to maintain the film thickness (Table 3).
Table 3.
Plasticizing temperature during extrusion of polymer films.
After extrusion, the thickness of the film was determined in accordance with ISO 4593 [32]. Foils received were from 0.023 to 0.050 mm thick.
Samples with dimensions of 50 mm × 50 mm (±2 mm) were prepared for biodegradability tests, according to the ISO 846 standard [14].
2.3. Wettability and Surface Energy
Wettability, especially hydrophilicity or hydrophobicity of a material, is a crucial factor in the biodegradation environment of living organisms. Therefore, water contact angle and surface energy (SE) of tested polymer foils were investigated. For contact angle measurement, a DSA 100 goniometer (Krüss GmbH, Hamburg, Germany) was used. The device was equipped with the automatic liquid drop dosing system. Contact angle measurements were made with a polar liquid—water. It was measured by placing the drops of the liquid onto the surface of foils and then measuring a series of contact angle values. For every sample, contact angles of three drops were obtained. For all values, arithmetic mean and standard mean deviation were calculated. These results were applied for the calculations of surface energy (SE) according to the Neumann method [33,34], using the Equation:
where γSl-SE corresponds to the solid–liquid interface, γS is the SE of a solid, γl is the SE of a measuring liquid, θ is the contact angle between the solid and the measuring liquid, and β2 = 0.0001057.
2.4. Biodegradability
For the assessment of biodegradability, the methodology based on method A, part of the ISO 846 standard, was used [14]. It is an international standard used to evaluate the growth of microorganisms on polymer materials. Method A concerns the evaluation of fungal growth. It assesses the degree of growth of the polymeric material samples by fungi in the presence of a mineral substrate, without glucose. Then, the only carbon source for the fungi becomes the polymeric material.
The standard provides the incubation of samples in the presence of a suspension of a mixture of fungal spores. The following model strains of mold fungi are used in the research: Aspergillus niger (ATCC 6275), Penicillium pinophilum (ATCC 36839), Paecilomyces variotii (ATCC 18502), Trichoderma virens (ATCC 9645), and Chaetomium globosum (ATCC 6205). It is known that fungi grow faster on polymer samples than bacteria, which makes it easier to observe their growth on samples during the assumed 28 days of incubation under laboratory conditions [12,35]. The fungi to be tested were grown in a Potato Dextrose Agar medium, PDA (Oxoid, Basingstoke, UK), at 29 °C, until the plate was outgrown by the developing mycelium. The spore mixture was prepared following the procedure described in the standard.
In order to bring laboratory tests closer to environmental conditions, similar tests were carried out in a soil solution, instead of a mineral medium with spores. The following parameters were used for the tests: pH, mg/L NO3, mg/L P, mg/L K, mg/L Mg, mg/L Ca, and salinity g NaCl/L. Soil tests were performed in an accredited external laboratory (Research Institute of Horticulture, Skierniewice, Poland). Additionally, the redox potential of the soil, as well as the total number of bacteria and fungi, were determined for the assessment of microbial activity. For this purpose, a soil solution was prepared. The soil was sieved through a sieve with a 2 mm mesh size. Then, 10 g of the soil was dissolved in 90 mL of sterile distilled water.
The redox potential was checked five times using the inoLab pH meter, pH 730, (WTW, Weilheim, Germany) equipped with a redox electrode.
In order to determine the total number of bacteria and fungi, inoculations were made using the serial dilution method (in the range of 10−1–10−6): (1) on a R2A medium (Oxoid, Basingstoke, UK) with chloramphenicol (Oxoid, Basingstoke, UK), in order to count the bacteria; (2) on a PDA medium (Oxoid, Basingstoke, UK) containing 0.1% of cycloheximide solution (Oxoid, Basingstoke, UK). Plates were incubated at 26 °C ± 1 °C for 5 days, after which bacterial colonies and fungi were counted. The tests were performed in triplicate.
Test films were sterilized for 15 min under UV light using a sterilizer (Beauty System NV208B, Wroclaw, Poland). Single foil samples were placed in sterile 90 mm diameter petri dishes, and then poured over with 15 mL of fungi suspension/soil solution. The samples were incubated for 28 days at 29 °C ± 1 °C and 95 ± 5% of relative humidity (RH) in a climatic chamber (Wamed KBK 30, Warszawa, Poland). After the exposure time, a visual inspection was made, then the samples were washed according to ISO 846 [14] and subjected to further analysis.
2.5. Visual and Microscopic Assessment
In addition to the visual assessment of the samples, documented photographically using an automatic colony counter (Interscience SCAN 1200, Saint-Nom-la-Bretèche, France), a microscopic analysis of the structural changes of the film surface was performed using a scanning electron microscope—SEM (Hitachi SU 8010, Tokio, Japan). Fragments of 20 mm × 20 mm in size were cut from the samples and sputtered with gold with a thickness of 1 nm using a gold sputtering coater (Cressington Sputter Coater 108 auto, Liverpool, UK) with a sputter thickness measurement module (Cressington Thickness Monitor MTM-10, Liverpool, UK). The photos were taken at a magnification of ×1000. Elemental analysis of the surface of the foil samples was performed using the Energy Dispersive X-ray Analysis, EDX, using the SEM-EDX (Thermo Scientific Ultra Dry, Waltham, MA, USA). The EDX spectrum of the sample surface allows semi-quantitative analysis of the elemental composition to a depth of about 1 µm [36]. During the EDX analysis, the preparations were subjected to the voltage of 20 kV and the intensity of 15 μA. Elemental analysis of the surface took 30 s at a magnification of ×1000 and a working distance of 15 mm. In order to show changes that may indicate the biodegradation of the film, changes in the content of O2 and C (wt%) of the analyzed samples were measured. The O/C ratio (%) of both elements was calculated. The increase in the value of this ratio is a determinant of the degradation processes [12].
2.6. Loss of Mass
The film pieces after visual inspection and washing (as described above) were weighed on an analytical balance with an accuracy of 0.001 g (Mettler Toledo MSI05DU, Greifensee, Switzerland). The mass loss expressed in % was the difference between the mass of the film before and after incubation in the presence of the fungus suspension/soil solution.
2.7. Fourier Transform Infrared Spectroscopy (FTIR)
The method of infrared spectroscopy (FTIR) with the reflection technique (ATR) was used. FTIR spectra were recorded in the range of 400–4000 cm−1 using a Cary 630 FTIR spectrometer (Agilent, Santa Clara, CA, USA) equipped with a diamond crystal (spectral resolution < 2 cm−1). In order to check the degree of PLA biodegradation, the carbonyl index (%) was used, which defines the ratio of the band intensity from the carbonyl group to the band intensity of the unchanged group during the biodegradation process [37]. The commencement of the biodegradation process manifests itself in an increased carbonyl index compared to the control samples, as a result of starting the oxidation. During the continuous contact of the polymeric material with biotic factors, its decomposition takes place, which results in a reduction in the number of carbonyl bonds, thus reducing the value of the carbonyl index.
3. Results
3.1. Preliminary Processing Assessment—Thermal Stability Measurement
Measurements of thermal stability were conducted on pure riboflavin, as well as neat PLA resin. Thermogravimetric curves are listed below (Figure 1).
Figure 1.
Thermogravimetric curves (TG/DTG) for (a) riboflavin (b) neat PLA, respectively.
Riboflavin as an additive shows positive processing properties. Very interesting is the fact that riboflavin has high, as for organic substances, thermal stability (271.89 °C), and does not show degradation in much of the so-called PLA ‘processing window’: the temperature range of processing from 155 °C (melt temperature) to the beginning decomposition (306.1 °C). However, in PLA processing, temperatures almost never exceed 250 °C, so riboflavin is an excellent additive in terms of processing.
3.2. Films
After extrusion of the granulate mixtures, films with a thickness of 23 to 50 µm were obtained. As expected, the addition of talc colored the material white, and the addition of riboflavin yellow. The appearance of the samples is shown in Figure 2.
Figure 2.
Photos of PLA samples modified with talc and riboflavin. Abbreviations: as in Table 2.
3.3. Preliminary Biodegradability Assessment—Contact Angle and Surface Energy
Wettability, especially hydrophilicity or hydrophobicity of a material, is a crucial factor in the biodegradation environment of living organisms. Therefore, water contact angle and surface energy (SE) of tested polymer foils were investigated. As presented in Table 4, both talc and riboflavin did not significantly affect surface hydrophilicity and SE.
Table 4.
Samples and raw materials used for the research.
Only a slight increase of surface energy is observed in foils A2, A3, and B3, which can be beneficial for better adhesion of microorganisms to these samples. Hydrophilic samples have a better affinity with microorganisms, which also contain water in their living structures. From that point of view, samples A2, A3 and B3 present slightly better surface thermodynamic states with respect to biodegradation affinity, as compared with other samples. Surface energy testing shows slight changes of parameters in comparison to pure PLA.
3.4. Research on Biodegradability
3.4.1. Soil Activity
For the soil used for the tests, the determined redox potential was 280 mV ± 5.9. On the other hand, the number of microorganisms in the soil was determined at the level of 25 × 104 cfu/mL bacteria and 11 × 104 cfu/mL of fungi.
3.4.2. Visual and Microscopic Assessment
Visual analysis of the samples after incubation with the fungi showed no significant differences. Contrary to the samples incubated in the soil solution, which, depending on the type and amount of the modifier (talc/riboflavin) showed differences in the amount of sediment on the film samples., the amount of soil sediment was directly proportional to the % of modifier content (Figure 3). Approximated overgrown area of samples is listed below the abbreviations.
Figure 3.
Visual analysis of samples after incubation: (a) with fungi and (b) with soil, with approximated overgrown area of samples (below abbreviations). Abbreviations: as in Table 2.
Detailed observation of the surface of the samples was conducted using SEM. For samples incubated with fungi, a sediment from the medium containing mineral salts was observed, which, despite repeated cleaning of the film, was permanently attached to its surface. This phenomenon was observed especially for samples A1, B2, and B3. Extensive convexities were observed on samples A2 and B1. The most significant changes were observed on the samples with the highest modifier content (A3 and B3). On these samples, structures that could indicate the formation of biofilm, which partially penetrated into the sample, and local cracks were observed (Figure 4a).


Figure 4.
SEM analysis of samples after incubation: (a) with fungi and (b) with soil. Abbreviations: as in Table 2. Control: sample not subjected to incubation.
More intense changes were observed on the surface of the samples incubated in the soil solution than in the presence of fungi. As for fungi, these changes became more spectacular with increasing modifier content. Much more intense changes of a similar nature were observed in samples containing riboflavin (B1–B3) than in talc (A1–A3). Already at the lowest (1%) concentrations, bubbles and structures were observed on the surface of the samples, which could indicate the formation of biofilm (A1 and B1). Additionally, on sample B2, numerous bacterial colonies and soil sediment were observed, while on sample B3, apart from those mentioned, there were cracks. On the A2 samples, there were areas with soil sediment, which on A3 samples took the form of regular networks. Probably, the sediment was related to the mycelium hyphae that were washed out during sample cleaning (Figure 4b).
Based on EDX analysis, the O/C ratio of both elements was calculated. After incubation with fungi, only for samples modified with the highest concentration of talc (A3), a significant increase in the parameter (by approx. 51%) was found, indicating biodegradation changes. For samples incubated in the soil solution, a significant increase in O/C was found for all modified samples. After the application of the highest concentration of modifiers, this increase was the most significant: by approx. 127% for samples with talc (A3) and by approx. 188% for samples with riboflavin (B3) (Figure 5).
Figure 5.
O/C ratio after incubation of the samples with fungi or in the soil solution in relation to the control samples. *—statistically significant difference based on the one-way ANOVA analysis. Abbreviations: as in Table 2.
3.4.3. Loss of Weight
Based on the measurement of the weight loss of the samples determined in accordance with ISO 846 [14], slight differences were found in relation to the control samples, a maximum of approx. 0.5% for the B1 sample containing riboflavin. It is assumed that this may be related to the problematic deposition of mainly soil sediment on the surface of the samples (Figure 6).
Figure 6.
Mass loss (%) of the samples after incubation with fungi or in the soil solution, compared to the control samples. *—statistically significant difference based on the one-way ANOVA analysis. Abbreviations: as in Table 2.
3.4.4. Fourier Transform Infrared Spectroscopy (FTIR)
The following bands were identified in the PLA spectrum: 1746 cm−1—vibrations of the C=O; 1450 cm−1—asymmetric vibrations of the CH3; 1265 cm−1, 1179 cm−1, 1126 cm−1, 1078 cm−1, and 1041 cm−1 O-C-C stretching vibrations; 866 cm−1—vibrations of the group of O-CH2-CH3; 753 cm−1 and 701 cm−1—deformation vibrations αCH3 [38]. The focus was on the region of the carbonyl group at 1746 cm−1, which is prone to the degradation processes. The carbonyl index was calculated in relation to the asymmetric vibrations CH3 groups at 1450 cm−1.
For all types of samples, both incubated in the presence of fungi and in the presence of soil solution, a decrease in the value of the carbonyl index was noted. However, the greatest decrease in this parameter, indicating degradation changes, was observed for samples with the highest concentration of talc (A3) incubated in the presence of soil solution (−28%), and for samples with the highest concentration of riboflavin (B3), both incubated in the presence of fungi (−27%) and soil solution (−33%) (Figure 7).
Figure 7.
Carbonyl index (%) of samples after incubation with fungi or in soil solution in relation to control samples. *—statistically significant difference based on the one-way ANOVA analysis. Abbreviations: as in Table 2.
4. Discussion
Riboflavin as an additive shows positive processing properties. Good thermal stability was highlighted in thermogravimetry analysis, as well as in the extrusion composite and film preparation, proving that riboflavin is outstanding addition in terms of processing. There is no thermogravimetric curve of talc powder in this work due to its wide description on in the literature [39,40].
Biodegradation of unmodified PLA has been the subject of intensive research for several years [18,41,42]. Rudeekit [43] checked the degree of biodegradation in various environments and showed that degradation of PLA in natural conditions of landfills and sewage treatment plants requires a much longer time than composting, especially under controlled laboratory conditions [43]. After a 4-month composting process in accordance with ISO 14855, they found the degree of biodegradation of PLA film at the level of 86%, which was the best result obtained [44]. On the other hand, [7] they found no degradation of PLA after a 6-week incubation in compost soil. Therefore, it was very important to check how the addition of talc and riboflavin would affect the biodegradation of the polymer material, which, as shown by other studies, contrary to expectations, is not easily degraded in the environment in its pure form.
Undoubtedly, the key allies in terms of the accelerated degradation processes are, among others, high temperature and microbial activity [45,46,47]. The importance of microorganisms in the decomposition of polymeric materials is also evidenced by the standards developed in the plastics industry, in which the resistance of materials is assessed on the basis of the growth of pure cultures of bacteria and fungi. The resistance of polymeric materials, and hence, the susceptibility to degradation by microorganisms, can be qualitatively assessed using techniques to assess microbial growth. After a specified period of time, the increase in the number or mass of cells is assessed, as well as the size of the growing colony area on the sample [14,48]. The biodegradation of polymers can additionally be assessed by measuring chemical properties, formation of new products, and deterioration of physical properties [49].
Despite the validity of conducting research in accordance with the reference strains of bacteria or fungi indicated in the standards, researchers checking biodegradation in situ indicate that in order to understand the impact of polymeric materials on the entire soil ecosystem, it is necessary to understand the mechanisms of the impact of such wastes on living organisms, including microorganisms, invertebrates, and plants [50]. It has also been shown that the presence of polymers in soil, especially PLA, has influences, among others, on soil pH and the number of soil microorganisms [20]. However, a comparison of the biodegradation process of unmodified PLA in garden soil and in compost soil with the use of the same microorganisms showed differences in the rate of changes taking place on plastics [12,20]. Hence, for the repeatability of research, it is also justified to conduct laboratory tests under controlled conditions, with reference strains, in a medium with specific components. In our research, we checked the biodegradability of the polymer material in both aspects: (1) under standardized conditions, in the presence of fungal strains; (2) under conditions as close as possible to standardized conditions, in a soil solution with tested parameters.
The first stage of the research was to analyze the wettability of the samples after extrusion. A significant increase in this parameter for samples containing talc or riboflavin led to the assumption that these samples would more easily adhere to microorganisms and thus biodegrade faster. The preliminary visual of the samples after incubation with microorganisms and the visual of the samples after incubation confirmed the assumptions. The observed amount of soil sediment on the samples, increasing with the content of the modifier (talc/riboflavin), may indicate improved adhesive properties of the modified materials. The adhesion of microorganisms to the surface of a polymer material is the first essential element of biofilm formation [51,52]. The presence of microorganisms strongly associated with the surface of the samples, especially those with the highest of the 20% content of talc or riboflavin used, was confirmed by microscopic analysis (SEM). Detailed analysis showed that on the samples containing riboflavin, the observed changes in the form of bubbles, cracks, and protrusions were more intense than for samples with talc with the same percentage content. According to the authors, the growth of microorganisms, including fungi, may cause bubbles, cavities, and cracks after penetrating into the polymer structure [53,54,55]. It has been proven that the intensive growth of many fungi on the surface of a polymeric material can cause swelling and cracking as the fungi penetrate into the structure of the material [56].
More intense changes were observed on the surface of the samples incubated in the soil solution than in the presence of fungi. Until 2006, Tritirachium album was the only L-PLA degrading fungus described [57], while Bajer [50] found that when testing samples based on the ISO 846 standard, it is easier and faster to observe the growth of fungi than bacteria [35].
As a result of the decomposition of polymers by hydrolysis and subsequent oxidation, the optical, mechanical, and electrical properties of the biological system change. Some of these changes can be observed using microscopic techniques in the form described [58,59]. However, they need to be confirmed by quantitative methods.
Other analyses, including EDX, also showed more intense degradation processes for samples after incubation in soil solution than for reference fungi, where significant changes were observed only for samples containing 20% talc. For samples incubated in soil, the most intense increase in the O/C ratio (by approx. 188%), indicating material degradation, was also observed for samples containing 20% riboflavin. In our research, we observed an increase in the value of the O/C ratio, the most significant for the highest levels of additives. This is typical of the initial stage of PLA biodegradation and may be due to an increase in the number of carboxylic acid end groups in the molecular structure as a result of ester bond hydrolysis [60]. Varesano observed the increase in the O/C ratio for PP samples, and confirmed that these were degradative changes with further studies [61]. A similar methodology to determine the degradation changes of PLA incubated in soil was used by Lv [60], although they found slight changes (approx. 0.06) in the O/C ratio after 105 days. Dąbrowska [55] recognized the potential of soil bioaugumentation with strains of Bacillus sp. bacteria while observing a 3% increase in O/C for pure PLA.
In our study, slight differences were noted when assessing the weight loss of the samples (max. 0.5% for samples containing riboflavin). When looking at the sediment visible during the surface analysis of the samples, confirmed by SEM analysis, the actual weight loss is probably much greater. The changes noticeable in the values of the loss of mass are important, but they are flawed with errors, as evidenced by, for example, the values of the standard deviation. The highest value of weight loss was observed for the samples containing the lowest concentration of riboflavin; however, no statistically significant differences were found between this value and the variants with the highest content of both additives. When reviewing the literature, it was found that the weight loss of PLA at the same time as our research is much greater during enzymatic degradation [62,63]. On the other hand, Morawska and Krasowska [64], checking the biodegradation of PLA in an environment enriched with a commercial microbiological preparation containing lactic acid bacteria, found a loss of film weight by about 30% after 8 weeks of incubation in a liquid medium.
Using the FTIR method, by comparing the intensity of the absorbance of the bands at the wavelength characteristic for carbonyl groups with the ratio of the absorbance of the bands at the wavelength assigned to specific systems, it can be stated that the share of C=O groups is reduced. The degradation of PLA takes place in the first stage by hydrolysis, which does not significantly change the content of carbonyl groups in the mass of the polymer. However, the progressive degradation process leads to the formation of appropriately short polymer chains and then mineralization, the effect of which is, among others, reduction of carbonyl groups, which can be quantified by the carbonyl index. For all modified samples, a decrease in the value of the carbonyl index was noted, which proves a positive effect of talc and riboflavin on biodegradation. The most promising in this respect were samples containing 20% of one of the additives (approx. 30% decrease in the parameter compared to the control). Similarly to the previous analyzes, stronger changes were observed in the presence of soil than in the presence of fungal strains. It is a very important analysis that significantly confirms the degradation potential of the material, because, among others, Sedničková et al. [41], after the biodegradation of PLA in compost at 58 °C for 16 days, and despite the observation of the loss of molecular weight, observed no significant changes in FTIR spectra.
The globally increasing demand for polymer materials is causing the growing problem of plastic accumulation in the environment. This is becoming a real threat to humans and the environment [65]. Modification of biodegradable plastics by adding non-degradable ingredients hinders biodegradation processes and leads to the formation of persistent pollutants. Additionally, it turns out that bioplastics are also difficult to degrade under conditions of storage in soil. Our solution, consisting in the modification of PLA by the addition of talc or riboflavin, accelerates the biodegradation process, additionally allowing the modification of its color.
5. Conclusions
Research has confirmed that PLA is not a readily biodegradable material. Adding talc or riboflavin increases biodegradability; the more of additive, the faster the processes, which is especially visible in samples containing riboflavin. In the presented studies, riboflavin was proved to be excellent in processability by extrusion techniques; moreover, it contributes to more intense degradation processes than talc, despite a slightly lower wettability, as resulting from contact angle measurements. In the light of the obtained results, it is necessary to investigate the possibility of using such a modification of PLA in-industry for specific applications. It is possible to further modify the PLA depending on the target application, including by adding antimicrobials, flame retardants, etc.
Author Contributions
Conceptualization, N.P. and P.R.; methodology, N.P., P.R. and K.J.; software, N.P. and K.J.; validation, P.R. and M.M.; formal analysis, P.R., K.F. and M.M.; investigation, N.P., P.R., K.J. and K.F.; resources, N.P., P.R. and K.J.; data curation, P.R. and K.J.; writing-original draft preparation, N.P., K.J. and K.F.; writing—review and editing, N.P., K.J. and K.F.; visualization, N.P. and K.J.; supervision, N.P. and P.R.; project administration, P.R. and N.P.; funding acquisition, N.P. and P.R. All authors have read and agreed to the published version of the manuscript.
Funding
This research received no external funding.
Institutional Review Board Statement
Not applicable.
Informed Consent Statement
Not applicable.
Data Availability Statement
The data presented in this study are available on request from the corresponding author.
Conflicts of Interest
The authors declare no conflict of interest.
References
- Bhiogade, A.; Kannan, M.; Devanathan, S. Degradation Kinetics Study of Poly Lactic Acid(PLA) Based Biodegradable Green Composites. Mater. Today Proc. 2020, 24, 806–814. [Google Scholar] [CrossRef]
- Polman, E.M.N.; Gruter, G.-J.M.; Parsons, J.R.; Tietema, A. Comparison of the Aerobic Biodegradation of Biopolymers and the Corresponding Bioplastics: A Review. Sci. Total Environ. 2021, 753, 141953. [Google Scholar] [CrossRef] [PubMed]
- Weligama Thuppahige, V.T.; Karim, M.A. A Comprehensive Review on the Properties and Functionalities of Biodegradable and Semibiodegradable Food Packaging Materials. Compr. Rev. Food Sci. Food Saf. 2022, 21, 689–718. [Google Scholar] [CrossRef] [PubMed]
- Kang, H.; Li, Y.; Gong, M.; Guo, Y.; Guo, Z.; Fang, Q.; Li, X. An Environmentally Sustainable Plasticizer Toughened Polylactide. RSC Adv. 2018, 8, 11643–11651. [Google Scholar] [CrossRef]
- Plastics and Environmental Sustainability by Andrady, Anthony L. (9781118312605)|BrownsBfS. Available online: https://www.brownsbfs.co.uk/Product/Andrady-Anthony-L/Plastics-and-environmental-sustainability---fact-and-fiction/9781118312605 (accessed on 19 February 2022).
- Suaria, G.; Avio, C.G.; Mineo, A.; Lattin, G.; Magaldi, M.; Belmonte, G.; Moore, C.; Regoli, F.; Aliani, S. The Mediterranean Plastic Soup: Synthetic Polymers in Mediterranean Surface Waters. Sci. Rep. 2016, 6, 37551. [Google Scholar] [CrossRef]
- Ohkita, T.; Lee, S.-H. Thermal Degradation and Biodegradability of Poly (Lactic Acid)/Corn Starch Biocomposites. J. Appl. Polym. Sci. 2006, 100, 3009–3017. [Google Scholar] [CrossRef]
- Stasiek, A.; Raszkowska-Kaczor, A.; Janczak, K. Foaming of poylactide. Przem. Chem. 2014, 93, 117–119. [Google Scholar] [CrossRef]
- Shimao, M. Biodegradation of Plastics. Curr. Opin. Biotechnol. 2001, 12, 242–247. [Google Scholar] [CrossRef]
- Ciriminna, R.; Pagliaro, M. Biodegradable and Compostable Plastics: A Critical Perspective on the Dawn of Their Global Adoption. ChemistryOpen 2020, 9, 8–13. [Google Scholar] [CrossRef]
- Kalita, N.K.; Damare, N.A.; Hazarika, D.; Bhagabati, P.; Kalamdhad, A.; Katiyar, V. Biodegradation and Characterization Study of Compostable PLA Bioplastic Containing Algae Biomass as Potential Degradation Accelerator. Environ. Chall. 2021, 3, 100067. [Google Scholar] [CrossRef]
- Janczak, K.; Hrynkiewicz, K.; Znajewska, Z.; Dąbrowska, G. Use of Rhizosphere Microorganisms in the Biodegradation of PLA and PET Polymers in Compost Soil. Int. Biodeterior. Biodegrad. 2018, 130, 65–75. [Google Scholar] [CrossRef]
- Castro-Aguirre, E.; Auras, R.; Selke, S.; Rubino, M.; Marsh, T. Insights on the Aerobic Biodegradation of Polymers by Analysis of Evolved Carbon Dioxide in Simulated Composting Conditions. Polym. Degrad. Stab. 2017, 137, 251–271. [Google Scholar] [CrossRef]
- ISO 846:2019—Evaluation of the Action of Microorganisms. Available online: https://www.iso.org/standard/74599.html (accessed on 19 November 2021).
- Stepczyńska, M.; Rytlewski, P. Enzymatic Degradation of Flax-Fibers Reinforced Polylactide. Int. Biodeterior. Biodegrad. 2018, 126, 160–166. [Google Scholar] [CrossRef]
- Standau, T.; Zhao, C.; Murillo Castellón, S.; Bonten, C.; Altstädt, V. Chemical Modification and Foam Processing of Polylactide (PLA). Polymers 2019, 11, 306. [Google Scholar] [CrossRef]
- Pasanphan, W.; Haema, K.; Kongkaoroptham, P.; Phongtamrug, S.; Piroonpan, T. Glycidyl Methacrylate Functionalized Star-Shaped Polylactide for Electron Beam Modification of Polylactic Acid: Synthesis, Irradiation Effects and Microwave-Resistant Studies. Polym. Degrad. Stab. 2021, 189, 109619. [Google Scholar] [CrossRef]
- Elmowafy, E.M.; Tiboni, M.; Soliman, M.E. Biocompatibility, Biodegradation and Biomedical Applications of Poly(Lactic Acid)/Poly(Lactic-Co-Glycolic Acid) Micro and Nanoparticles. J. Pharm. Investig. 2019, 49, 347–380. [Google Scholar] [CrossRef]
- Hammiche, D.; Amar, B.; Bettache, A.; Budtova, T.; Guermazi, N. Characterization of Polylactic Acid Green Composites and Its Biodegradation in a Bacterial Environment. Int. J. Polym. Anal. Charact. 2019, 24, 236–244. [Google Scholar] [CrossRef]
- Janczak, K.; Dąbrowska, G.B.; Raszkowska-Kaczor, A.; Kaczor, D.; Hrynkiewicz, K.; Richert, A. Biodegradation of the Plastics PLA and PET in Cultivated Soil with the Participation of Microorganisms and Plants. Int. Biodeterior. Biodegrad. 2020, 155, 105087. [Google Scholar] [CrossRef]
- Sinclair, R.G. The Case for Polylactic Acid as a Commodity Packaging Plastic. J. Macromol. Sci. Part A 1996, 33, 585–597. [Google Scholar] [CrossRef]
- Mousa, N.; Galiwango, E.; Haris, S.; Al-Marzouqi, A.H.; Abu-Jdayil, B.; Caires, Y.L. A New Green Composite Based on Plasticized Polylactic Acid Mixed with Date Palm Waste for Single-Use Plastics Applications. Polymers 2022, 14, 574. [Google Scholar] [CrossRef]
- Młotek, M.; Gadomska-Gajadhur, A.; Sobczak, A.; Kruk, A.; Perron, M.; Krawczyk, K. Modification of PLA Scaffold Surface for Medical Applications. Appl. Sci. 2021, 11, 1815. [Google Scholar] [CrossRef]
- Fiedurek, K.; Szroeder, P.; Macko, M.; Raszkowska-Kaczor, A.; Puszczykowska, N. Influence of the Parameters of the Extrusion Process on the Properties of PLA Composites with the Addition of Graphite. IOP Conf. Ser. Mater. Sci. Eng. 2021, 1199, 012057. [Google Scholar] [CrossRef]
- Królikowski, B.; Kaczmarek, H.; Klimiec, E.; Chylińska, M.; Bajer, D. Wpływ struktury na właściwości piezoelektryczne elektretów polipropylen-montmorylonit. Polimery 2019, 64, 493–498. [Google Scholar] [CrossRef]
- Zenker, B.; Dannemann, M.; Geller, S.; Holeczek, K.; Weißenborn, O.; Altinsoy, M.E.; Modler, N. Structure-Integrated Loudspeaker Using Fiber-Reinforced Plastics and Piezoelectric Transducers—Design, Manufacturing and Validation. Appl. Sci. 2020, 10, 3438. [Google Scholar] [CrossRef]
- Kovalcik, A.; Pérez-Camargo, R.A.; Fürst, C.; Kucharczyk, P.; Müller, A.J. Nucleating Efficiency and Thermal Stability of Industrial Non-Purified Lignins and Ultrafine Talc in Poly(Lactic Acid) (PLA). Polym. Degrad. Stab. 2017, 142, 244–254. [Google Scholar] [CrossRef]
- Shakoor, A.; Thomas, N.L. Talc as a Nucleating Agent and Reinforcing Filler in Poly(Lactic Acid) Composites. Polym. Eng. Sci. 2014, 54, 64–70. [Google Scholar] [CrossRef]
- Li, B.; Hu, X.; Zhang, Q.; Peng, X.; Xiang, Y. Improved Piezoelectricity of Polylactide Using Vitamin B2 for Poling-Free Mechanical and Acoustic Nanogenerators. J. Mater. Sci. 2021, 56, 902–912. [Google Scholar] [CrossRef]
- ISO 1133-1:2011—Determination of the Melt Mass-Flow Rate (MFR) and Melt Volume-Flow Rate (MVR) of Thermoplastics—Part 1: Standard Method. Available online: https://www.iso.org/standard/44273.html (accessed on 19 November 2021).
- PN-EN ISO 11358:2004—Thermogravimetry (TG) of Polymers. Available online: https://sklep.pkn.pl/pn-en-iso-11358-2004p.html (accessed on 19 November 2021).
- PN-ISO 4593:1999—Plastics—Film and Sheeting—Determination of Thickness by Mechanical Scanning. Available online: https://sklep.pkn.pl/pn-iso-4593-1999p.html (accessed on 19 November 2021).
- Żenkiewicz, M. Methods for the Calculation of Surface Free Energy of Solids. J. Achiev. Mater. Manuf. Eng. 2007, 24, 137–145. [Google Scholar]
- Rytlewski, P.; Żenkiewicz, M. Applications of Lasers in Metallization of Thermoplastic and Thermosetting Polymers. J. Achiev. Mater. Manuf. Eng. 2013, 57, 9. [Google Scholar]
- Bajer, K.; Richert, A.; Bajer, D.; Korol, J. Biodegradation of Plastified Starch Obtained by Corotation Twin-Screw Extrusion. Polym. Eng. Sci. 2012, 52, 2537–2542. [Google Scholar] [CrossRef]
- Hockaday, W.C.; Grannas, A.M.; Kim, S.; Hatcher, P.G. The Transformation and Mobility of Charcoal in a Fire-Impacted Watershed. Geochim. Cosmochim. Acta 2007, 71, 3432–3445. [Google Scholar] [CrossRef]
- Bajer, K.; Kaczmarek, H. Metody badania biodegradacji materiałów polimerowych. Cz. II. Techniki eksperymentalne. Polimery 2007, 52, 13–18. [Google Scholar] [CrossRef]
- Vijayakumar, S.; Rajakumar, P.R. Infrared Spectral Analysis of Waste Pet Samples. Int. Lett. Chem. Phys. Astron. 2012, 4, 58–65. [Google Scholar] [CrossRef]
- Piga, L.; Villieras, F.; Yvon, J. Thermogravimetric Analysis of a Talc Mixture. Thermochim. Acta 1992, 211, 155–162. [Google Scholar] [CrossRef]
- Lee, C.; Pang, M.M.; Koay, S.C.; Choo, H.L.; Tshai, K.Y. Talc Filled Polylactic-Acid Biobased Polymer Composites: Tensile, Thermal and Morphological Properties. SN Appl. Sci. 2020, 2, 354. [Google Scholar] [CrossRef]
- Sedničková, M.; Pekařová, S.; Kucharczyk, P.; Bočkaj, J.; Janigová, I.; Kleinová, A.; Jochec-Mošková, D.; Omaníková, L.; Perďochová, D.; Koutný, M.; et al. Changes of Physical Properties of PLA-Based Blends during Early Stage of Biodegradation in Compost. Int. J. Biol. Macromol. 2018, 113, 434–442. [Google Scholar] [CrossRef]
- Boey, J.Y.; Mohamad, L.; Khok, Y.S.; Tay, G.S.; Baidurah, S. A Review of the Applications and Biodegradation of Polyhydroxyalkanoates and Poly(Lactic Acid) and Its Composites. Polymers 2021, 13, 1544. [Google Scholar] [CrossRef]
- Rudeekit, Y.; Numnoi, J.; Tajan, M.; Chaiwutthinan, P.; Leejarkpai, T. Determining Biodegradability of Polylactic Acid under Different Environments. J Met. Mater. Min. 2008, 18, 83–87. [Google Scholar]
- ISO 14855:2018 Determination of the Ultimate Aerobic Biodegradability of Plastic Materials under Controlled Composting Conditions—Method by analysis of Evolved Carbon Dioxide. Available online: https://www.iso.org/standard/72046.html (accessed on 19 November 2021).
- Kumar, S.; Maiti, P. Controlled Biodegradation of Polymers Using Nanoparticles and Its Application. RSC Adv. 2016, 6, 67449–67480. [Google Scholar] [CrossRef]
- Milošević, M.; Krkobabić, A.; Radoičić, M.; Šaponjić, Z.; Radetić, T.; Radetić, M. Biodegradation of Cotton and Cotton/Polyester Fabrics Impregnated with Ag/TiO2 Nanoparticles in Soil. Carbohydr. Polym. 2017, 158, 77–84. [Google Scholar] [CrossRef]
- Tarani, E.; Črešnar, K.P.; Zemljič, L.; Chrissafis, K.; Papageorgiou, G.; Lambropoulou, D.; Zamboulis, A.; Bikiaris, D.N.; Terzopoulou, Z. Cold Crystallization Kinetics and Thermal Degradation of PLA Composites with Metal Oxide Nanofillers. Appl. Sci. 2021, 11, 3004. [Google Scholar] [CrossRef]
- Calmon, A.; Dusserre-Bresson, L.; Bellon-Maurel, V.; Feuilloley, P.; Silvestre, F. An Automated Test for Measuring Polymer Biodegradation. Chemosphere 2000, 41, 645–651. [Google Scholar] [CrossRef]
- Zumstein, M.T.; Narayan, R.; Kohler, H.-P.E.; McNeill, K.; Sander, M. Dos and Do Nots When Assessing the Biodegradation of Plastics. Environ. Sci. Technol. 2019, 53, 9967–9969. [Google Scholar] [CrossRef] [PubMed]
- Chae, Y.; An, Y.-J. Current Research Trends on Plastic Pollution and Ecological Impacts on the Soil Ecosystem: A Review. Environ. Pollut. Barking Essex 1987 2018, 240, 387–395. [Google Scholar] [CrossRef]
- Rabin, N.; Zheng, Y.; Opoku-Temeng, C.; Du, Y.; Bonsu, E.; Sintim, H.O. Biofilm Formation Mechanisms and Targets for Developing Antibiofilm Agents. Future Med. Chem. 2015, 7, 493–512. [Google Scholar] [CrossRef]
- Misic, C.; Covazzi Harriague, A. Development of Marine Biofilm on Plastic: Ecological Features in Different Seasons, Temperatures, and Light Regimes. Hydrobiologia 2019, 835, 129–145. [Google Scholar] [CrossRef]
- Loredo-Treviño, A.; Garcia, G.; Velasco-Téllez, A.; Rodríguez-Herrera, R.; Aguilar, C.N. Polyurethane Foam as Substrate for Fungal Strains. Adv. Biosci. Biotechnol. 2011, 2, 52. [Google Scholar] [CrossRef]
- Valapa, R.B.; Pugazhenthi, G.; Katiyar, V. Hydrolytic Degradation Behaviour of Sucrose Palmitate Reinforced Poly(Lactic Acid) Nanocomposites. Int. J. Biol. Macromol. 2016, 89, 70–80. [Google Scholar] [CrossRef]
- Dąbrowska, G.B.; Janczak, K.; Richert, A. Combined Use of Bacillus Strains and Miscanthus for Accelerating Biodegradation of Poly (Lactic Acid) and Poly (Ethylene Terephthalate). PeerJ 2021, 9, e10957. [Google Scholar] [CrossRef]
- Kannahi, M.; Thamizhmarai, T. Biodegradation of Plastic by Aspergillus sp. Int. J. Trend Sci. Res. Dev. 2018, 2, 683–690. [Google Scholar]
- Tokiwa, Y.; Calabia, B.P. Biodegradability and Biodegradation of Poly(Lactide). Appl. Microbiol. Biotechnol. 2006, 72, 244–251. [Google Scholar] [CrossRef] [PubMed]
- Rajkumar, M.; Nagendran, R.; Lee, K.J.; Lee, W.H.; Kim, S.Z. Influence of Plant Growth Promoting Bacteria and Cr6+ on the Growth of Indian Mustard. Chemosphere 2006, 62, 741–748. [Google Scholar] [CrossRef] [PubMed]
- Kalitkiewicz, A.; Kępczyńska, E. The Use of Rhizobacteria in Plant Growth Promoting Process. Biotechnologia 2008, 2, 102–114. [Google Scholar]
- Lv, S.; Liu, X.; Gu, J.; Jiang, Y.; Tan, H.; Zhang, Y. Microstructure Analysis of Polylactic Acid-Based Composites during Degradation in Soil. Int. Biodeterior. Biodegrad. 2017, 122, 53–60. [Google Scholar] [CrossRef]
- Varesano, A.; Dall’Acqua, L.; Tonin, C. A Study on the Electrical Conductivity Decay of Polypyrrole Coated Wool Textiles. Polym. Degrad. Stab. 2005, 89, 125–132. [Google Scholar] [CrossRef]
- Lee, S.H.; Kim, I.Y.; Song, W.S. Biodegradation of Polylactic Acid (PLA) Fibers Using Different Enzymes. Macromol. Res. 2014, 22, 657–663. [Google Scholar] [CrossRef]
- Bubpachat, T.; Sombatsompop, N.; Prapagdee, B. Isolation and Role of Polylactic Acid-Degrading Bacteria on Degrading Enzymes Productions and PLA Biodegradability at Mesophilic Conditions. Polym. Degrad. Stab. 2018, 152, 75–85. [Google Scholar] [CrossRef]
- Morawska, M.; Krasowska, K. Degradability of Polylactide Films by Commercial Microbiological Preparations for Household Composters. Pol. J. Chem. Technol. 2017, 19, 44–48. [Google Scholar] [CrossRef][Green Version]
- Vince, J.; Hardesty, B.D. Plastic Pollution Challenges in Marine and Coastal Environments: From Local to Global Governance. Restor. Ecol. 2017, 25, 123–128. [Google Scholar] [CrossRef]
Publisher’s Note: MDPI stays neutral with regard to jurisdictional claims in published maps and institutional affiliations. |
© 2022 by the authors. Licensee MDPI, Basel, Switzerland. This article is an open access article distributed under the terms and conditions of the Creative Commons Attribution (CC BY) license (https://creativecommons.org/licenses/by/4.0/).